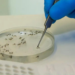
Minas registra mais duas mortes por dengue em 2025; outras 37 são investigadas

No início da noite de ontem (4), por volta das 19 horas, a Polícia Militar foi acionada a comparecer ao bairro São Lucas, onde havia ocorrido um acidente de trânsito entre duas motocicletas, sendo uma Yamaha Lander XTZ 250 e uma Sundow Max 125. A primeira conduzida por um homem de 18 anos e a segunda, por um de 47 anos.
Os envolvidos já haviam sido socorridos pela equipe do SAMU e conduzidos ao hospital. Testemunhas disseram à polícia que a colisão entre as motocicletas foi lateral, nos cruzamentos entre a avenida Laura Andrade e rua Breno Albuquerque de Oliveira.
O local foi isolado para os trabalhos periciais e mais tarde a PM foi informada que o cidadão de 47 anos não resistiu aos ferimentos e veio a óbito. O outro envolvido, de 18 anos, é inabilitado e depois do atendimento médico foi preso em flagrante e conduzido à delegacia de Polícia Civil, em Formiga.
Não foram divulgadas fotos do ocorrido.
Fonte: Agência Local de Comunicação Organizacional 63°BPM

Discussão sobre isso post